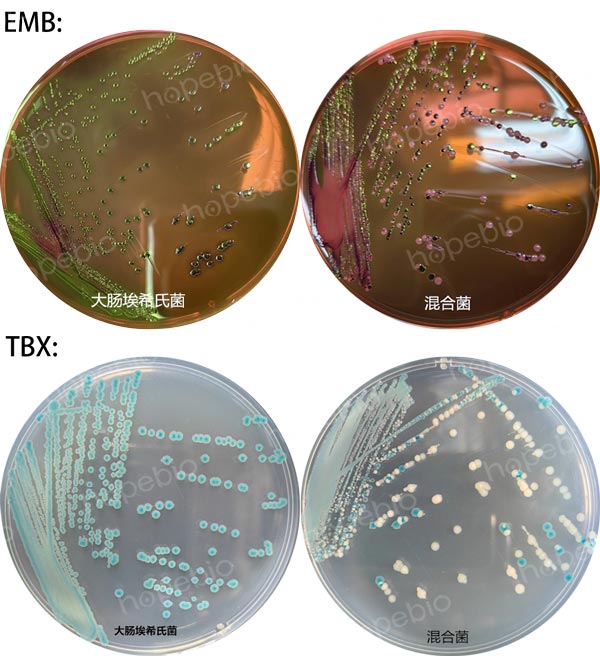
EMB和TBX培养基上大肠埃希氏菌的菌落特征和分离效果 EMB和TBX培养基上大肠埃希氏菌的菌落特征和分离效果
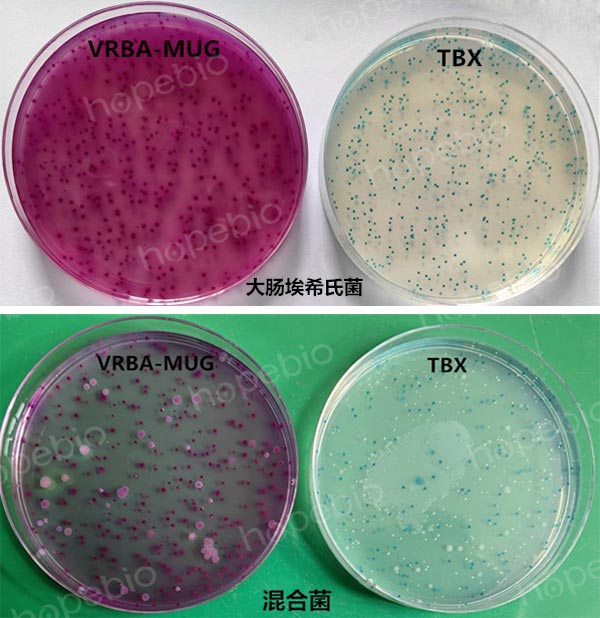
图4-1  大肠埃希氏菌的生长特征和混合菌分离效果
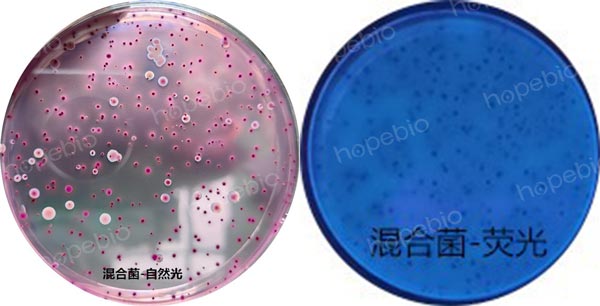
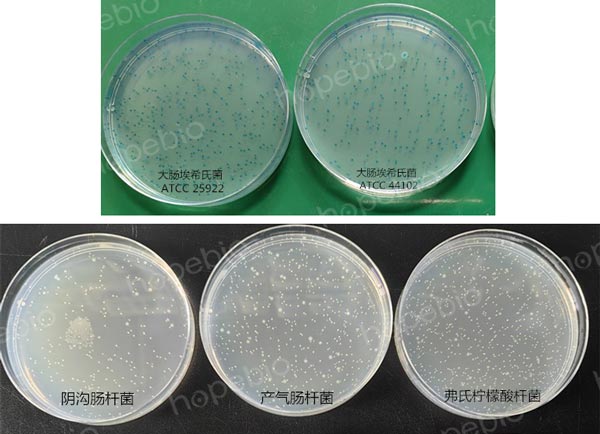
图5  TBX培养基上大肠埃希氏菌和其它肠杆菌科细菌的特征

海博微信公众号
海博微信公众号
 海博天猫旗舰店
海博天猫旗舰店


 海博微信公众号
海博微信公众号
 海博天猫旗舰店
海博天猫旗舰店




一、标准简介
GB 4789.38 《食品安全国家标准 食品微生物学检验 大肠埃希氏菌计数》,通过样品中大肠杆菌的计数多少,作为粪便污染指标来评价食品的卫生状况,推断食品中肠道致病菌污染的可能性。
2023年2月10日,食品安全国家标准审评委员会秘书处就《食品安全国家标准 食品微生物学检验 大肠埃希氏菌计数》等38项食品安全国家标准和修改单(征求意见稿)征集意见,截止日期为2023年3月20日。现将GB 4789.38(征求意见稿)与GB 4789.38-2012进行比对探讨。
二、变化要点
《GB4789.38 食品安全国家标准 食品微生物学检验 大肠埃希氏菌计数》中,有关大肠埃希氏菌的计数共涉及两种方法:MPN法和平板法,这在两个版本中是一致的。但每种方法的检验程序和操作步骤都有变化,相应的培养基、设备、相关试剂和附录也都有所更改。详细如下:
1、MPN法检验程序

图1 大肠埃希氏菌MPN计数法检验程序(左:2012版 右:征求意见版)
MPN法总共分三个步骤,初发酵、复发酵和分离鉴定。从图1对比可以看出,有关分离鉴定这一步,现行标准中是采用先在EMB平板上进行划线培养,根据菌落特征挑取可疑菌落进行纯化,进一步生化试验进行鉴定,判断结果;在征求意见稿中则直接采用划线TBX平板进行培养的方法。
有关大肠埃希氏菌在所涉及的两种培养基(EMB和TBX)上的生长状态和分离效果如图2所示:
图2 EMB和TBX培养基上大肠埃希氏菌的菌落特征和分离效果
2、平板计数法
现行标准中,是“将10 mL~15 mL冷至45℃±0.5℃的结晶紫中性红胆盐琼脂(VRBA)倾注于每个平皿中。小心旋转平皿,将培养基与样品匀液充分混匀。待琼脂凝固后,再加3 mL~4 mL VRBA-MUG覆盖平板表层。凝固后翻转平板,36℃±1℃培养18 h~24 h。选择菌落数在10 CFU~100 CFU之间的平板,暗室中360 nm~366 nm 波长紫外灯照射下,计数平板上发浅蓝色荧光的菌落。”其中主要用到了VRBA、VRBA-MUG培养基,同时需要紫外灯照射相配合的形式,进行菌落计数。
而在征求意见稿中,则只使用TBX倾注培养的方式即可根据菌落特征进行计数(如图3)。

图3 大肠埃希氏菌平板计数法检验程序(左:2012版 右:征求意见稿)
有关大肠埃希氏菌及混合菌在所涉及的两种培养基(VRBA-MUG和TBX)上倾注培养后的生长状态如图4所示:
图4-1 大肠埃希氏菌的生长特征和混合菌分离效果
图4-2 VRBA-MUG上的混合菌在自然光和紫外光下的状态
三、讨论
两个版本相比,修改意见稿中通过对TBX的引入,使两种方法的检验程序都简化了很多。从检验效果来看,也能达到计数的目的,甚至优于之前的方法。这种改变是基于目前市场已经拥有质量过关、使用效果较好的TBX培养基为基础的。实验室人员在购买TBX培养基时,一定要选择质量可靠的厂家,避免对检验结果造成影响。
我公司生产的TBX试验效果如图5所示:
图5 TBX培养基上大肠埃希氏菌和其它肠杆菌科细菌的特征
相关产品:
结晶紫中性红胆盐-4-甲基伞形酮-β-D-葡萄糖苷琼脂(VRBA-MUG)-点击查看产品详情
注:本文属海博生物原创,未经允许不得转载。
上一篇:样品中大肠埃希氏菌的分离方法解读
| 相关文章: | ||



